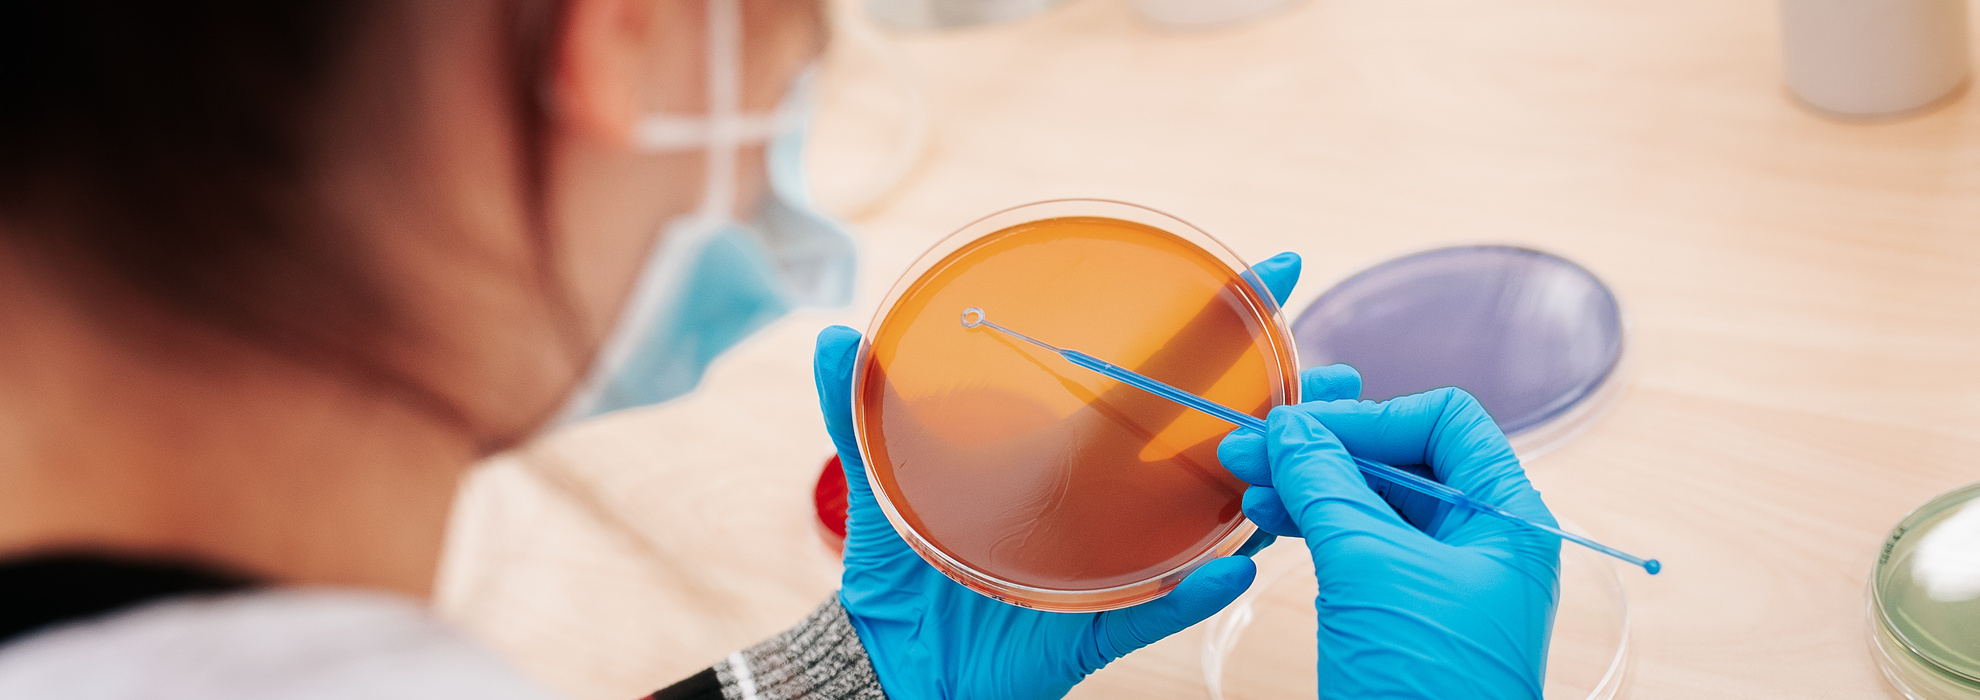
bioanalüütik

Otsing

Olete oodatud 20. juunil 2024. aastal osalema Tartu Tervishoiu Kõrgkooli (Nooruse 5) lõpuaktustel. Aktustest on ka ülekanne veebi.
- Kell 11.00 toimub aktus rakenduskõrghariduse õppekavade lõpetajatele.
- Kell 14.00 toimub aktus kutsehariduse õppekavade lõpetajatele.
Rõõmsa kohtumiseni!
Eelmised sündmused
13. aprill 2024
Bioanalüütikute päev 2024
13. aprill 2024